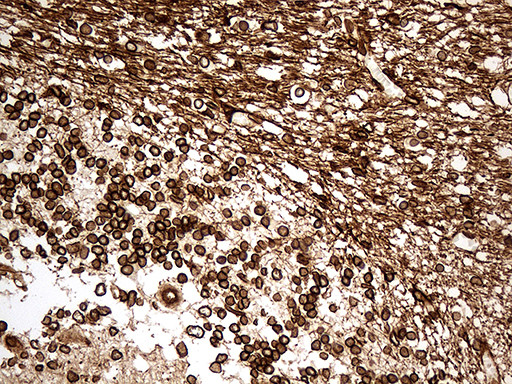
NF Antibody in Immunohistochemistry (Paraffin) (IHC (P))

Search
OriGene
NF Monoclonal Antibody (OTI3F7), TrueMAB™
{{$productOrderCtrl.translations['antibody.pdp.commerceCard.promotion.promotions']}}
{{$productOrderCtrl.translations['antibody.pdp.commerceCard.promotion.viewpromo']}}
{{$productOrderCtrl.translations['antibody.pdp.commerceCard.promotion.promocode']}}: {{promo.promoCode}} {{promo.promoTitle}} {{promo.promoDescription}}. {{$productOrderCtrl.translations['antibody.pdp.commerceCard.promotion.learnmore']}}
图: 1 / 5
NF Antibody (CF190077) in IHC (P)





产品信息
CF190077
宿主/亚型
分类
类型
克隆号
抗原
偶联物
形式
浓度
规格
保存条件
运输条件
产品详细信息
Synthetic peptide sequence is EYQDLLNVKMALDIEIAAYRKLLEGEE
For reconstitution, we recommend adding 100 µL distilled water to a final antibody concentration of about 1 mg/mL. To use this carrier-free antibody for conjugation experiments, we strongly recommend performing another round of desalting. (Zeba Spin Desalting Columns, 7KMWCO, 0.5 mL, Product # 89882)
靶标信息
Neurofilaments are type IV intermediate filament heteropolymers composed of light, medium, and heavy chains. Neurofilaments comprise the axoskeleton and functionally maintain neuronal caliber. They may also play a role in intracellular transport to axons and dendrites. This gene encodes the medium neurofilament protein. This protein is commonly used as a biomarker of neuronal damage. Alternative splicing results in multiple transcript variants encoding distinct isoforms. Diseases associated with NEFM include Pineal Parenchymal Tumor Of Intermediate Differentiation and Wallerian Degeneration. Among its related pathways are Amyotrophic lateral sclerosis (ALS) and Neural Stem Cell Differentiation Pathways and Lineage-specific Markers. Gene Ontology (GO) annotations related to this gene include structural molecule activity and structural constituent of cytoskeleton.
仅用于科研。不用于诊断过程。未经明确授权不得转售。